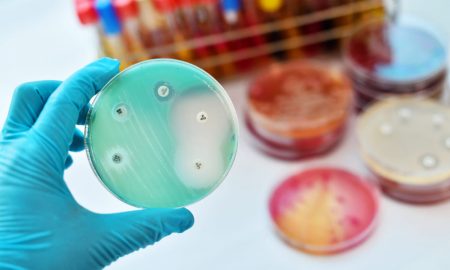
testare rezistenta bacteriana

All posts tagged "antibiotice"
-

 354Actualitate
354ActualitateBrazilia trebuie să dovedească că nu folosește antibiotice pentru a exporta carne către UE
Comisia Europeană a confirmat miercuri că Brazilia a fost exclusă de pe lista țărilor autorizate să exporte carne și produse de origine...
-
717Actualitate
717ActualitateBacteriile rezistente la antibiotice: de ce apar și cum ne putem proteja eficient?
Te-ai confruntat vreodată cu o infecție care nu răspunde la tratamentul recomandat? Fenomenul bacteriilor rezistente la antibiotice are un impact tot mai...
-

 652Business
652BusinessAntibiotice Iaşi se pregăteşte să exporte cel puţin două noi produse în Australia
Producătorul de medicamente Antibiotice Iaşi, deţinut de Ministerul Sănătăţii, şi-a propus iniţierea înregistrării a cel puţin două noi produse în Australia, unde...
-

 807Business
807BusinessCompania Antibiotice a raportat un profit net de 87,9 milioane lei, în creştere cu 15%
Compania Antibiotice a înregistrat, în primele nouă luni ale acestui an, un profit net de de 87,9 milioane lei, în creştere cu...











